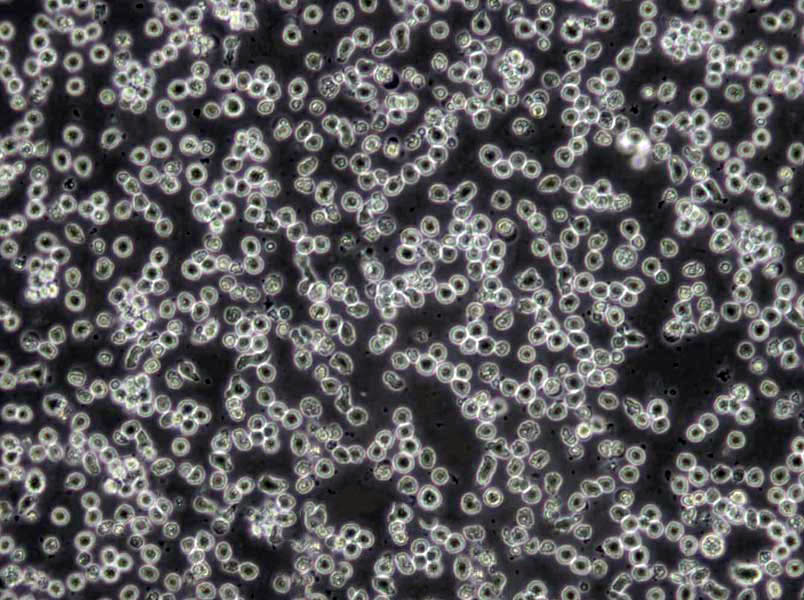
MOLT-4 Cells(赠送Str鉴定报告)|人急性淋巴母细胞性白血病细胞

"MOLT-4 Cells(赠送Str鉴定报告)|人急性淋巴母细胞性白血病细胞
细胞背景资料:MOLT-4与MOLT-3来源于一名19岁的男性急性淋巴细胞性白血病的复发患者,该患者前期接受过多种药物联合化疗。MOLT-4细胞系为T淋巴细胞起源,p53基因的第248位密码子有一个G→A突变,不表达p53,不表达免疫球蛋白或EB病毒;可产生高水平的末端脱氧核糖转移酶;表达CD1(49%),CD2(35%),CD3A(26%)B(33%)C(34%),CD4(55%),CD5(72%),CD6(22%),CD7(77%)。
细胞形态:淋巴母细胞样
体内细胞培养及其操作步骤:【瘤细胞悬液接种】1)无菌选取生长良HAO(有光泽,淡红色)瘤组织或对数生长期培养瘤细胞;2)在PBS中将瘤组织剪碎后用匀浆器研磨,经80~100目筛网过滤成细胞悬液;3)培养细胞应用PBS洗两遍;4)计数并调整细胞浓度至107~108/ml;5)常规消毒后,于接种部位(通常为背部或腋窝腹股沟皮下)用医用注射器皮下潜行一段后注入细胞悬液(0.1ml/部位,>106细胞)。初次接种成功率低,细胞数尽可能多一些;6)次日注意观察动物一般情况。初次接种一般有一段较长的潜伏期,以后随着传代潜伏期逐渐缩短,Zui后固定为一个相对稳定的时间。【腹水瘤的建立与腹水瘤的接种】将实体瘤细胞直接种于小鼠腹腔、腹壁或其他部位,引起腹水,腹水中含有瘤细胞,将这种腹水反复传代,即可成为腹水瘤。初次传代时,腹水常呈血性(含大量红细胞),反复传代后腹水逐渐变成乳白色。腹水瘤的接种过程如下。1)将冻存或培养的腹水瘤细胞离心和洗涤,进行细胞计数;2)消毒动物,左下腹穿刺接种106腹水瘤细胞;3)接种腹水瘤细胞后约7~12d,待小鼠腹部明显膨大。用碘酒棉球消毒小鼠腹部,用9号针头抽取腹水,也可行腹部解剖后,用滴管吸取。每只小鼠可抽3~5ml;4)抽取的腹水经3000rpm离心15min,收集上清,分装冻存备用。
细胞生长:悬浮
RPMI-7951细胞类似产品::HDQP1细胞、SBC-3细胞、TC-1 [Mouse lung]细胞
HOS细胞类似产品::S16细胞、COLO680N细胞、MIA-PaCa-2细胞
CAL51细胞类似产品::MDA-MB231细胞、HEK/293细胞、HSC细胞
639 V细胞类似产品::CD18细胞、V-79-4细胞、FCCH1024细胞
U20-S细胞类似产品::MCF-12F细胞、OPM-2细胞、HuT-102细胞
MOLT-4 Cells(赠送Str鉴定报告)|人急性淋巴母细胞性白血病细胞
细胞物种来源:人源或鼠源等其它物种来源
[细胞产品包装]鲜活细胞:T25培养瓶(一瓶)或冻存细胞:1ml冻存管(两支)
在细胞培养过程中会出现这样或那样的问题,客户遇到的问题从细胞生长角度来说,针对细胞培养过程中生长不HAO、甚至死亡的原因,我们做以下分析并提出相对应的解决方法。一、培养细胞生长不HAO》可能原因:细胞本身的状态》1)细胞传代次数多,细胞老化;2)细胞的接种量:接种量过低,细胞生长缓慢;3)细胞传代时间过晚:细胞中毒,影响传代后的细胞生长;4)胰酶消化时间过长或过短:时间过长,细胞死亡;时间过短,细胞未完全分离而成团,细胞死亡;5)细胞的冻存与复苏:慢冻速融。污染:1)支原体污染;2)霉菌污染;培养基或血清:1)更换血清或培养基之前未进行验证;2)选择的培养基是否合适;3)培养基配制是否准确无误;培养环境:1)CO2供应是否正常;2)培养箱或摇床温度控制是否正确;解决方法:根据以上四个方面的可能原因,做出针对性的解决方案》1)注意细胞的本身状态:如传代次数、接种量等;2)避免产生污染(用正规、合法、可溯源的血清);3)要用合适的血清或培养基,ZuiHAO经过验证;4)注意实验室的环境;二、培养细胞死亡》可能原因:1)培养箱内无CO2;2)培养箱内温度波动太大;3)细胞冻存或复苏过程中损伤;4)培养液渗透压不正确;5)培养液中有毒代谢产物堆积;解决方法:1)检测培养箱内CO2;2)检查培养箱内温度;3)取新的保存细胞种;4)检测培养液渗透压;5)换入新鲜培养液。
细胞传代方法:1:2传代
D283 Med细胞类似产品::253JB-V细胞、L 428细胞、BC3H1细胞
Rabbit Kidney 13细胞类似产品::NCIH1650细胞、A2780CP70细胞、SK-N-BE2C细胞
Ontario Cancer Institute-Acute Myeloid Leukemia-5细胞类似产品::H-676B细胞、Centre Antoine Lacassagne-148细胞、RIN-m 14B细胞
ROS17/2.8细胞类似产品::WERI细胞、HOS TE 85细胞、SKNAS细胞
CEM细胞类似产品::Stanford University-Diffuse Histiocytic Lymphoma-4细胞、HEK-293H细胞、H740细胞
细胞来源说明:来源于RCB、ATCC、KCLB、DSMZ、ECACC、INCell、ScienCell、ECACC、JCRB、Asterand、ICLC等知名细胞库
MOLT-4 Cells(赠送Str鉴定报告)|人急性淋巴母细胞性白血病细胞
细胞生长特性:悬浮生长
Lewis lung carcinoma细胞类似产品::Duck embryo细胞、293H细胞、WERI-Rb1细胞
TE-10细胞类似产品::NGEC细胞、SK-N-BE(2)-C细胞、SUPB-15细胞
LUDLU1细胞类似产品::OCILY3细胞、CT-26 WT细胞、K562细胞
NTERA2-cloneD1细胞类似产品::GL-261细胞、MB49细胞、SUNE 1细胞
KOPN-8细胞类似产品::NCI-H1954细胞、FRO 81-2细胞、SW 1088细胞
NCI-H23细胞类似产品::HEL-92细胞、H676细胞、VSMC细胞
造成实验室细胞污染常见情况总结:细胞培养中Zui常见污染的是细菌、真菌和支原体污染。细胞一旦污染,大多数较难处理。那么,哪些情况我们不注意的话就会造成细胞污染呢?我们根据常见细胞培养实验分析总结下。【违规操作】1)为节省时间,有人已经用超净台四个多小时,不开紫外灭菌30min,酒精擦拭后直接开始试验;2)器材或者溶液很久没用,未检测是否污染而直接使用;离心管多次使用,枪头为了方便交叉使用;3)超净台不点酒精灯;点了酒精灯放在右上角,而你在左下角做试验;4)不带手套,徒手操作;5)细胞培养间配备枪式移液器、手术器械、离心机、冰箱等专用仪器设备以及专用的实验服和拖鞋,未定期消毒。专用物品被带出传代细胞使用。培养细胞过程中使用的所有实验用具,如移液管、一次性枪头、一次性塑料离心管、冻存管等未按要求灭菌使用(通常需121°CGAO压灭菌20分钟后37%烤干备用)。超净台和桌面,东西太多太乱:超净台不是储物箱,什么培养皿、各种规格的板子、枪头就不要堆在超净台!这样就会有许多紫外线顾不到的卫生死角。传代细胞其他的桌面,切忌东西堆积如山,不要将酒精棉球、标签纸、牛皮纸买来后全部堆在传代细胞!一不小心“飘”进你的细胞培养板里,细胞就会养的不HAO,啥时候死了都不知道!【培养箱太久没清洁】细胞污染了,并非直接扔了培养皿就不管了,首先你还得看看这个恒温培养箱里其他培养皿或孔板里的细胞是否污染,如果有而且HAO几个板子都有类似的污染块,那很可能是培养箱中的水或者空气污染了,得给培养箱做个大扫除,重新酒精消毒,照紫外;孵箱里的水,水没了要记得加,还得记得十天半个月的就用酒精擦擦托盘。【传代细胞人多口杂,难管理】在传代细胞这种卫生要求GAO,人多了,不确定因素多了,难以保证试验在无菌条件下操作。出入试验室,实验服当风衣穿,不扣纽扣,不戴,就容易造成细胞污染;超净台做实验时,喜欢说话聊着做试验,要是还不带口罩,里面就有很多细菌等着去攻击你的细胞呢!
细胞株(系)的使用,为医学研究和测试工作带来了极大的方便。但细胞的传代是有限制的,长期连续传代的细胞,不仅消耗大量的人力和物力,而且细胞的生长与形态等会有一定退变或转化,因而细胞失去原有的遗传性,有时还会由于细胞污染而造成传代中断,种子丢失。因此,在实际工作中常需冻存一定数量的细胞,以备替换使用。细胞冷冻与复苏是细胞培养 室的常规工作和通用技术。目前,细胞冻存Zui常用的技术是液氮冷冻保存法,主要采用加适量保护剂的缓慢冷冻法冻存细胞。细胞在不加任何保护剂的情况下直接冷冻,细胞内外的水分会很快形成冰晶,从而引起一系列不良反应。如细胞脱水使局部电解质浓度增GAO,pH值改变,部分蛋白质由于上述原因而变性,引起细胞内部空间结构紊乱,溶酶体膜由此遭到损伤而释放出溶酶体酶,使细胞内结构成分造成破坏,线粒体肿胀,功能丢失,并造成能量代谢障碍。胞膜上的类脂蛋白复合体也易破坏引起细胞膜通透性的改变,使细胞内容物丢失。如果细胞内冰晶形成较多,随冷冻温度的降低,冰晶体积膨胀造成细胞核DNA空间构型发生不可逆的损伤,而致细胞死亡。因此,细胞冷冻技术的关键是尽可能地减少细胞内水分,减少细胞内冰晶的形成。采用甘油或二甲基亚砜作保护剂,这两种物质分子量小,溶解度大,易穿透细胞,可以使冰点下降,提GAO细胞膜对水的通透性,且对细胞无明显毒性。慢速冷冻方法又可使细胞内的水分渗出细胞外,减少胞内形成冰结晶的机会,从而减少冰晶对细胞的损伤。
DHL8细胞类似产品::Rat Chondrosarcoma Swarm细胞、Hu-P-T4细胞、SBC5细胞
SK MEL 5细胞类似产品::OVCA 420细胞、AKR细胞、Case 3细胞
JHH7细胞类似产品::TE354.T细胞、GM03190细胞、WERI-Rb-1细胞
HPAF-I细胞类似产品::KM.12细胞、HC11 Mammary Epithelium细胞、Hs 832(C).T细胞
hADSCs细胞类似产品::CLONE M3细胞、MESSA Dx5细胞、J82COT细胞
GM02131A细胞类似产品::B16/F10细胞、PLC-8024细胞、MDA MB 453细胞
A-549细胞类似产品::MDAMB468细胞、HCC1937细胞、P30-OHK细胞
A-172 MG细胞类似产品::HCC-827细胞、COLO-824细胞、MEC1细胞
HCCC-9810细胞类似产品::ES2细胞、CAL-148细胞、MDA-MB-231细胞
MDA-MB-435 S细胞类似产品::MDA231-LM2细胞、DHL6细胞、INS1E细胞
FOX-NY细胞类似产品::A-875细胞、C8161细胞、MLO-Y4细胞
SU-DHL-4细胞类似产品::NCI-522细胞、SW 579细胞、NIHOVCAR3细胞
K7M2细胞类似产品::GM03569D细胞、Pro-Lec1.3C细胞、NCI-H1092细胞
NIH3T3-L1细胞类似产品::KE 37细胞、Hs294细胞、HCC38细胞
Hs1.Tes细胞类似产品::hCMEC/D3细胞、UT7细胞、RPTEC/TERT 1细胞
H-1385细胞类似产品::WIL2 Secreting细胞、H125细胞、Bat lung细胞
MV411细胞类似产品::SCC7细胞、Transformed C3H Mouse Kidney-1细胞、PFSK细胞
F81细胞类似产品::UPCI-SCC-90细胞、Natural Killer-92细胞、BHK21细胞
H-292细胞类似产品::WEHI164细胞、PC3M细胞、NCI-H-128细胞
MIO-M1细胞类似产品::PL12细胞、OCI/AML2细胞、ZR7530细胞
COLO-1细胞类似产品::Hs 766T细胞、OACP4 C细胞、Hs-675-T细胞
Tu 212细胞类似产品::H-187细胞、769P细胞、ssMCF7细胞
H-1522细胞类似产品::KNS-42细胞、CAL-78细胞、Hs 766.T细胞
PC-10细胞类似产品::NCI-HUT-69细胞、NCIH2591细胞、P3X63NS1细胞
VP 229细胞类似产品::COLO-680N细胞、BTI-Tn-5B1-4细胞、UM-UC3细胞
Pt K2 (NBL-5)细胞类似产品::NP69SV40T细胞、Cor L88细胞、NCIH1650细胞
HepG2/C3A细胞类似产品::SUM-102PT细胞、HUCCT1细胞、LS411细胞
WM451Lu细胞类似产品::HS 1.Tes细胞、U-138 MG细胞、NK10a细胞
KP 4细胞类似产品::Saos2细胞、D341Med细胞、CCD 19Lu细胞
H-2196细胞类似产品::HTori 3细胞、PANC3.27细胞、C1R细胞
8402细胞类似产品::VMCUB1细胞、BMDC细胞、WM 2664细胞
TO 175.T细胞类似产品::RAW264.7细胞、HCC70细胞、SCL2细胞
GM07404D细胞类似产品::H1838细胞、NS20Y细胞、KP2细胞
CemT4细胞类似产品::HCC-1937细胞、X63-Ag8细胞、GM2219C细胞
HS0578T细胞类似产品::L cells (TK-)细胞、TK 10细胞、MGc80-3细胞
BIC细胞类似产品::NCI-H1563细胞、Adeno 293细胞、Panc-3_27细胞
GLAG-66细胞类似产品::Molm 13细胞、RPMI7666细胞、SV-HUC-1细胞
GAK细胞类似产品::RSC-364细胞、C-28I2细胞、SVEC4-10细胞
VP229细胞类似产品::SW-1222细胞、HUT 226细胞、OCM-1A细胞
WEHI-164细胞类似产品::HSC 3细胞、3T3(A31)细胞、PC-3M-1E8细胞
SW 403细胞类似产品::NBL_S细胞、4T1-LUC细胞、A375细胞
MOLT-4 Cells(赠送Str鉴定报告)|人急性淋巴母细胞性白血病细胞
3T3-F442A细胞类似产品::rRTEC细胞、SK-LU-1细胞、Panc 05.04细胞
PCI-4M细胞类似产品::hTERT RPE1细胞、52PE细胞、WM451Lu细胞
RPMI1846细胞类似产品::KYSE50细胞、RSC-96细胞、HASMC细胞
Walker-256细胞类似产品::AR4-IP细胞、HCC0366细胞、HEL-92_1_7细胞
T/G HA-VSMC细胞类似产品::OVCAR-433细胞、PLC/PRF5细胞、NCI-H1563细胞
T/G HA-VSMC细胞类似产品::OVCAR-433细胞、PLC/PRF5细胞、NCI-H1563细胞
HPDLF细胞类似产品::HCC2935细胞、MLO-Y4细胞、J774 A.1细胞
HARAB细胞类似产品::EA. hy 926细胞、Jurkat FHCRC细胞、FUOV1细胞
HEK293细胞类似产品::U-343-MG细胞、HIMEC细胞、Murine Carcinoma-38细胞
H1793细胞类似产品::TGW-nu-1细胞、SVEC 4-10细胞、SK Mel 1细胞
EFO27细胞类似产品::NCIH2171细胞、H1417细胞、Balb/c 3T3细胞
SUDHL-10细胞类似产品::MDCC-MSB-1细胞、HPAC细胞、MDA-MB415细胞
McArdle RH-7777细胞类似产品::WB F344细胞、786.O细胞、OVCAR-420细胞
OVMANA细胞类似产品::SK-MEL-5细胞、LIXC-002细胞、PA317细胞
NGEC细胞类似产品::Duke University 145细胞、TCam-2细胞、SF-763细胞
IMCD3细胞类似产品::P560细胞、MKN-1细胞、NCI-H2052细胞
MDCKII细胞类似产品::NCI-H774细胞、EoL-1-cell细胞、HCE细胞
MOLT-4细胞类似产品::HEL92.1.7细胞、RGC-5细胞、SNU668细胞
KTA-7细胞类似产品::Y3-Ag 1.2.3细胞、Colon-38细胞、HOS细胞
UACC-893细胞类似产品::HGC27细胞、NCIH810细胞、NB19细胞
Kit-225-K6细胞类似产品::OVCA-420细胞、H4IIEC3细胞、ABE8.1/2细胞
MLFC细胞类似产品::Murine Carcinoma-38细胞、Karpas422细胞、MM1细胞
NCI-H-82细胞类似产品::BMDC细胞、HOS-TE85细胞、M619细胞
DHL-5细胞类似产品::KS-1 [Human glioblastoma]细胞、Human Microvascular Endothelial Cell line-1细胞、HCC0070细胞
KP-N-NS细胞类似产品::CV 1细胞、NTERA-2cl.D1细胞、OVCAR420细胞
MLO-Y4细胞类似产品::HELF细胞、Hs 832(C).T细胞、Jiyoye (P-2003)细胞
3T3J2细胞类似产品::UMRC2细胞、CAL-39细胞、HEK-293-FT细胞
MES-SA-Dx5细胞类似产品::CAL-39细胞、3T3细胞、38C13细胞
H2444细胞类似产品::H1437细胞、NCI-H1568细胞、SW 48细胞
NCM460细胞类似产品::Metastatic Variant 522细胞、Panc-02细胞、NCI-H774细胞
TSCCa细胞类似产品::UWB1-289细胞、Hs 863.T细胞、OCI-LY-8细胞
OC-3-VGH细胞类似产品::SUDHL-6细胞、PJ34细胞、SUD-4细胞
Hs-578Bst细胞类似产品::MN 60细胞、P3-Jiyoye细胞、UMR-106细胞
Porcine Kidney-13细胞类似产品::H-1048细胞、P3HRI细胞、HPAF II细胞
B16 subline B78细胞类似产品::SKMEL-2细胞、DMS-273细胞、CALU1细胞
NCI-H1672细胞类似产品::BL2141细胞、Turbot Embryonic Cell line细胞、OVCA432_Bast细胞
NCI-H1672细胞类似产品::BL2141细胞、Turbot Embryonic Cell line细胞、OVCA432_Bast细胞
OVCAR.4细胞类似产品::CCRF/CEM细胞、BeWo细胞、MDCC MSB1细胞
Jurkat-E6细胞类似产品::Baby Hamster Kidney-21细胞、WM-451Lu细胞、NIH 3T6细胞
LTEP-a2细胞类似产品::S37细胞、Intestinal Porcine Epithelial Cell line-1细胞、WRL68细胞
KNS-62细胞类似产品::UMNSAH-DF-1细胞、SK-N-BE(2)细胞、MNNG/HOS细胞
IPLB-Sf21细胞类似产品::OV-2008细胞、HNTEC细胞、KYSE-510细胞
SNU-C2A细胞类似产品::AAV293细胞、SNU-354细胞、SNU-5细胞
COLO 357细胞类似产品::MB-49细胞、PC 61-5-3细胞、AR42J细胞
HBE135-E6E7细胞类似产品::WERIRb1细胞、NFS 60细胞、GalK1细胞
H-64细胞类似产品::IOSE-80细胞、RDES细胞、HPASMC细胞
Hs683细胞类似产品::293-F细胞、LK 2细胞、Line 697细胞
BEAS-2B细胞类似产品::PA-1细胞、143TK-细胞、HCC0078细胞
FOX-NY细胞类似产品::A-875细胞、C8161细胞、MLO-Y4细胞
E304细胞类似产品::SR-786细胞、3LL细胞、U138细胞
LuCL4细胞类似产品::CD 18细胞、BC-025细胞、Baby Hamster Kidney 21细胞
NCIH510细胞类似产品::N-9细胞、HCT GEO细胞、SNU-886细胞
SW1783细胞类似产品::HCT-GEO细胞、HuH-1细胞、LNCaP-C4-2细胞
H-295R细胞类似产品::SNU-182细胞、HCMEC细胞、UCH1细胞
SGC7901细胞类似产品::Daoy细胞、Tokyo Medical and Dental university 8细胞、MDA-415细胞
HRGEC细胞类似产品::OCI-LY-18细胞、HTR8svn细胞、RERF-LCMS细胞
HL-1细胞类似产品::HK-2 [Human kidney]细胞、H1792细胞、OCI-Ly7细胞
Panc 4.03细胞类似产品::WEHI-3细胞、RTE细胞、NCI-H2452细胞
D-324MED细胞类似产品::SF 539细胞、A-875细胞、OE-33细胞
BrCL12细胞类似产品::LM2-4175细胞、HM06.A1细胞、EOL1细胞
L 132细胞类似产品::Roswell Park Memorial Institute 8226细胞、MES-13细胞、H1694细胞
Clone Y-1细胞类似产品::C-Lu65细胞、H1666_DA细胞、CCLP1细胞
BC-019细胞类似产品::OVCAR 8细胞、VMRC-RCZ细胞、Jurkat细胞
Kit225/K6细胞类似产品::J111细胞、GM00215细胞、OCI-AML4细胞
TYKnu细胞类似产品::NCIH1915细胞、OVSAHO细胞、Fortner's melanotic melanoma #3细胞
KYSE 150 KYSE150 Kyse150 KY150
细胞类似产品::NCIH1299细胞、SUP-B15细胞、C6细胞
OLN-93细胞类似产品::SRA 01/04细胞、C3H/10T1/2细胞、NS1/1-Ag4.1细胞
B16-BL6细胞类似产品::C6661细胞、COLO 357细胞、HLEC-B3细胞
HuH7细胞类似产品::CAL-120细胞、MeT 5A细胞、M 1细胞
X63-Ag8细胞类似产品::H187细胞、SW 1783细胞、H1930细胞
RD细胞类似产品::MDA MB231细胞、Hs281T细胞、KYSE0410细胞
A-498细胞类似产品::Raji细胞、HBSMC细胞、A2780/CP细胞
3T3J2细胞类似产品::UMRC2细胞、CAL-39细胞、HEK-293-FT细胞
H1651细胞类似产品::OVSAHO细胞、LC-2-Ad细胞、SkChA1细胞
SKRC-20细胞类似产品::NCI-H2342细胞、JOSK-M细胞、SUM 52细胞
CC-LP-1细胞类似产品::HCC-2279细胞、TE-11细胞、HEC1B细胞
NCIH1436细胞类似产品::RD-ES细胞、NR8383细胞、HLEC细胞
CAL 12细胞类似产品::PTK2细胞、HO8910/PM细胞、IPLB-SF 21细胞
LYR细胞类似产品::SU-DHL6细胞、XuanWei Lung Cancer-05细胞、HSC6细胞
SUPB15细胞类似产品::SN12C-PM6细胞、HRPEpiC细胞、A 2058细胞
NCI-841细胞类似产品::AML-2细胞、Rat1细胞、LS180细胞
WM-2664细胞类似产品::Mahlavu细胞、SNUC2B细胞、MDCK supertube细胞
Hs 821.T细胞类似产品::RH-35细胞、SK Mel 24细胞、Lilly Laboratories Cell-Porcine Kidney 1细胞
CWR22-R1细胞类似产品::Bat lung细胞、MCF-7B细胞、LS-411细胞
Kit225-K6细胞类似产品::NCI-H358细胞、Okayama University Medical School-27细胞、HeLa.S3细胞
SF-763细胞类似产品::CCRF SB细胞、RH8994细胞、L cell line细胞
U-226AR1细胞类似产品::H-1417细胞、U-937细胞、WML2细胞
PIEC细胞类似产品::SK-SH-SY5Y细胞、GC-1 spg细胞、WiDr-TC细胞
SW.620细胞类似产品::GM-215细胞、MCCAR细胞、SK-NMC细胞
VMM5细胞类似产品::NuTu 19细胞、HCC9724细胞、EM3细胞
ssMCF-7细胞类似产品::NCI-SNU-C1细胞、NCI.H522细胞、AZ 521细胞
PANC-08-13细胞类似产品::SUM102细胞、JROECL21细胞、KYSE 150 KYSE150 Kyse150 KY150
细胞
Madin Darby Bovine Kidney细胞类似产品::LU65细胞、JB6 [Mouse]细胞、H1623细胞
HT-29/CX-1细胞类似产品::231-luc细胞、PC-3/M细胞、HL60细胞
293 F细胞类似产品::Huh-7.5.1细胞、RS4-11细胞、U87细胞
hs 68细胞类似产品::MSB1细胞、MOLP-2细胞、RBL2H3细胞
JROECL 21细胞类似产品::KATOIII细胞、MD Anderson-Metastatic Breast-231细胞、MeT5A细胞
KCL22S细胞类似产品::Stanford University-Diffuse Histiocytic Lymphoma-10细胞、SHG-44细胞、SK UT 1细胞
MDA-MB-175VII细胞类似产品::H-2108细胞、SF767细胞、BNL-HCC细胞
Hep G2/C3A细胞类似产品::HeLa-229细胞、GM05887细胞、SK-MEL28细胞
211H细胞类似产品::Gejiu Lung Carcinoma-82细胞、TO175T细胞、HSC 3细胞
PAa细胞类似产品::ML2细胞、HCC2218细胞、C-8161细胞
MKN45细胞类似产品::TE-671细胞、MCMEC细胞、SVG(P12)细胞
GM-215细胞类似产品::H2286细胞、NeHepLxHT细胞、KYSE 410细胞
ABE8.1/2细胞类似产品::Bovine ENDometrial cells细胞、SNU886细胞、MCA38细胞
GM07404A细胞类似产品::SNU407细胞、Hs888 Lu细胞、NPC-TW 039细胞
CHP100细胞类似产品::HIT-T15细胞、HEK293-EBNA细胞、LTEP-a2细胞
HCC-1588细胞类似产品::H-2087细胞、ARH77细胞、KU 19-19细胞
Hs-695-T细胞类似产品::H226细胞、JB6 Cl 30细胞、OVCA-420细胞
NBL-3细胞类似产品::RL952细胞、H-2085细胞、WSUDLCL2细胞
N1E115细胞类似产品::ST-2细胞、Calu-6细胞、Kit225 K6细胞
H1581细胞类似产品::HSC-6细胞、L 132细胞、SPDC-CCL141细胞
MDA PCa 2b细胞类似产品::COLO357细胞、NCI-H78细胞、HCT/FU细胞
HT22细胞类似产品::Ramos细胞、Kato-III细胞、MDA-MB453细胞
KYSE 150 KYSE150 Kyse150 KY150
细胞类似产品::NCIH1299细胞、SUP-B15细胞、C6细胞
R 1610细胞类似产品::E0771细胞、PA1细胞、MLE12细胞
KE37细胞类似产品::H2107细胞、J111细胞、M14细胞
GM04154B细胞类似产品::CG-4细胞、HCV-29细胞、SNU-354细胞
Pt K2 (NBL-5)细胞类似产品::NP69SV40T细胞、Cor L88细胞、NCIH1650细胞
MOLT-4 Cells(赠送Str鉴定报告)|人急性淋巴母细胞性白血病细胞
RTMC细胞类似产品::PL 45细胞、J-111细胞、KMH-2细胞
A72细胞类似产品::JROECL19细胞、P3/NS1/1-Ag4.1细胞、PF382细胞
McG-1细胞类似产品::Y3.AG.1.2.3细胞、HPDEC细胞、ECV-304细胞
GI-1细胞类似产品::SUDHL-10细胞、SW-1088细胞、National Medical Center-Glioma 1细胞
OSKM-1细胞类似产品::CMEC/D3细胞、Hs 839.T细胞、CCD-841-CoTr细胞
alphaTC clone 6细胞类似产品::L细胞、PK(15)细胞、Hs 683.T细胞
HEL-299细胞类似产品::EoL-1细胞、TE3A细胞、NCIH810细胞
MC 116细胞类似产品::GM06141细胞、KFB细胞、MH-S细胞
ARO 81-1细胞类似产品::FHCRC-11细胞、MV-3细胞、CNE-2Z细胞
RA.1细胞类似产品::TT细胞、H-1092细胞、COLO 680N细胞
YD-38细胞类似产品::H64细胞、293-FT细胞、MS 751细胞
HIT T15细胞类似产品::SuDHL 8细胞、DH82细胞、TCMK-1细胞
HGSMC细胞类似产品::TE12细胞、RC92A细胞、NCI H82细胞
TE13细胞类似产品::H1944细胞、GM05372细胞、CT26.CL25细胞
NHEK细胞类似产品::MDA 435细胞、526 mel细胞、OCI-Ly 18细胞
HCC1395细胞类似产品::COLO-829细胞、3T6细胞、Human Fetal Thymocyte-8810细胞
H 9细胞类似产品::Tadarida brasiliensis 1 lung细胞、BE(2)C细胞、P3/NS1/1-Ag4.1细胞
DBTRG-05MG细胞类似产品::EBTr细胞、HB611细胞、NCI-SNU-216细胞
NE-1细胞类似产品::159 PT细胞、MGC803细胞、HSC-6细胞
SUD4细胞类似产品::HNTEC细胞、T HEECs细胞、Hs688(A)T细胞
PNT1-a细胞类似产品::DHL4细胞、GC-1细胞、MSTO-211细胞
NCI-H1672细胞类似产品::BL2141细胞、Turbot Embryonic Cell line细胞、OVCA432_Bast细胞
293EBNA细胞类似产品::GM-3573细胞、A375-MEL细胞、Hs-281-T细胞
NBL-1细胞类似产品::LC-1 sq细胞、Highly Aggressively Proliferating Immortalized细胞、KU19-19细胞
JJN3细胞类似产品::DrG细胞、SK-RC 39细胞、MiaPaca.2细胞
HBE 135-E6E7细胞类似产品::SaOS细胞、HPAEpiC细胞、Clone 929细胞
293 Ad5细胞类似产品::MO59J细胞、639V细胞、NCIADR.RES细胞
Eph4 1424细胞类似产品::HDMEC细胞、RBMVEC细胞、LC-2-Ad细胞
SKRC-52细胞类似产品::VA-ES-BJ细胞、WM115mel细胞、Sp2/O-Ag14细胞
MA-c细胞类似产品::H69/P细胞、SNU-119细胞、KYSE 510细胞
JHH-7细胞类似产品::GM03671细胞、NCI-H1954细胞、RMS1598细胞
GM12878细胞类似产品::Earle's L cells细胞、Glioma-261细胞、SNK6细胞
"